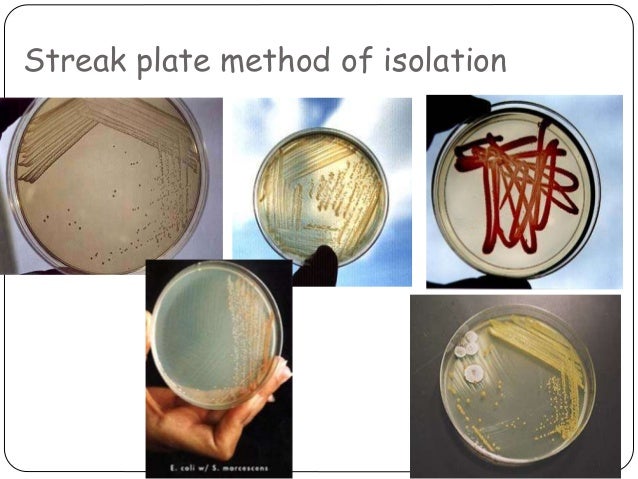

Contoh ujian personaliti, contoh ujian lisan spm, contoh uji t, contoh ujian ielts, contoh uji fisher, contoh uji tanda, contoh ujian psikologi, contoh uji korelasi, contoh uji hipotesis, contoh uji linearitas, contoh uji normalitas, contoh uji validitas, contoh ujian psikometrik, contoh uji independent, contoh uji homogenitas, contoh uji organoleptik, contoh ujian pembantu makmal c19, contoh uji regresi linier sederhana, contoh ujian apel 7, contoh ujian soal mtcna, contoh uji tanda statistik, contoh ujian tes kompetensi, contoh uji analisis jalur, contoh ujian proposal skripsi, contoh uji hipotesis spss 23,
Random Image










